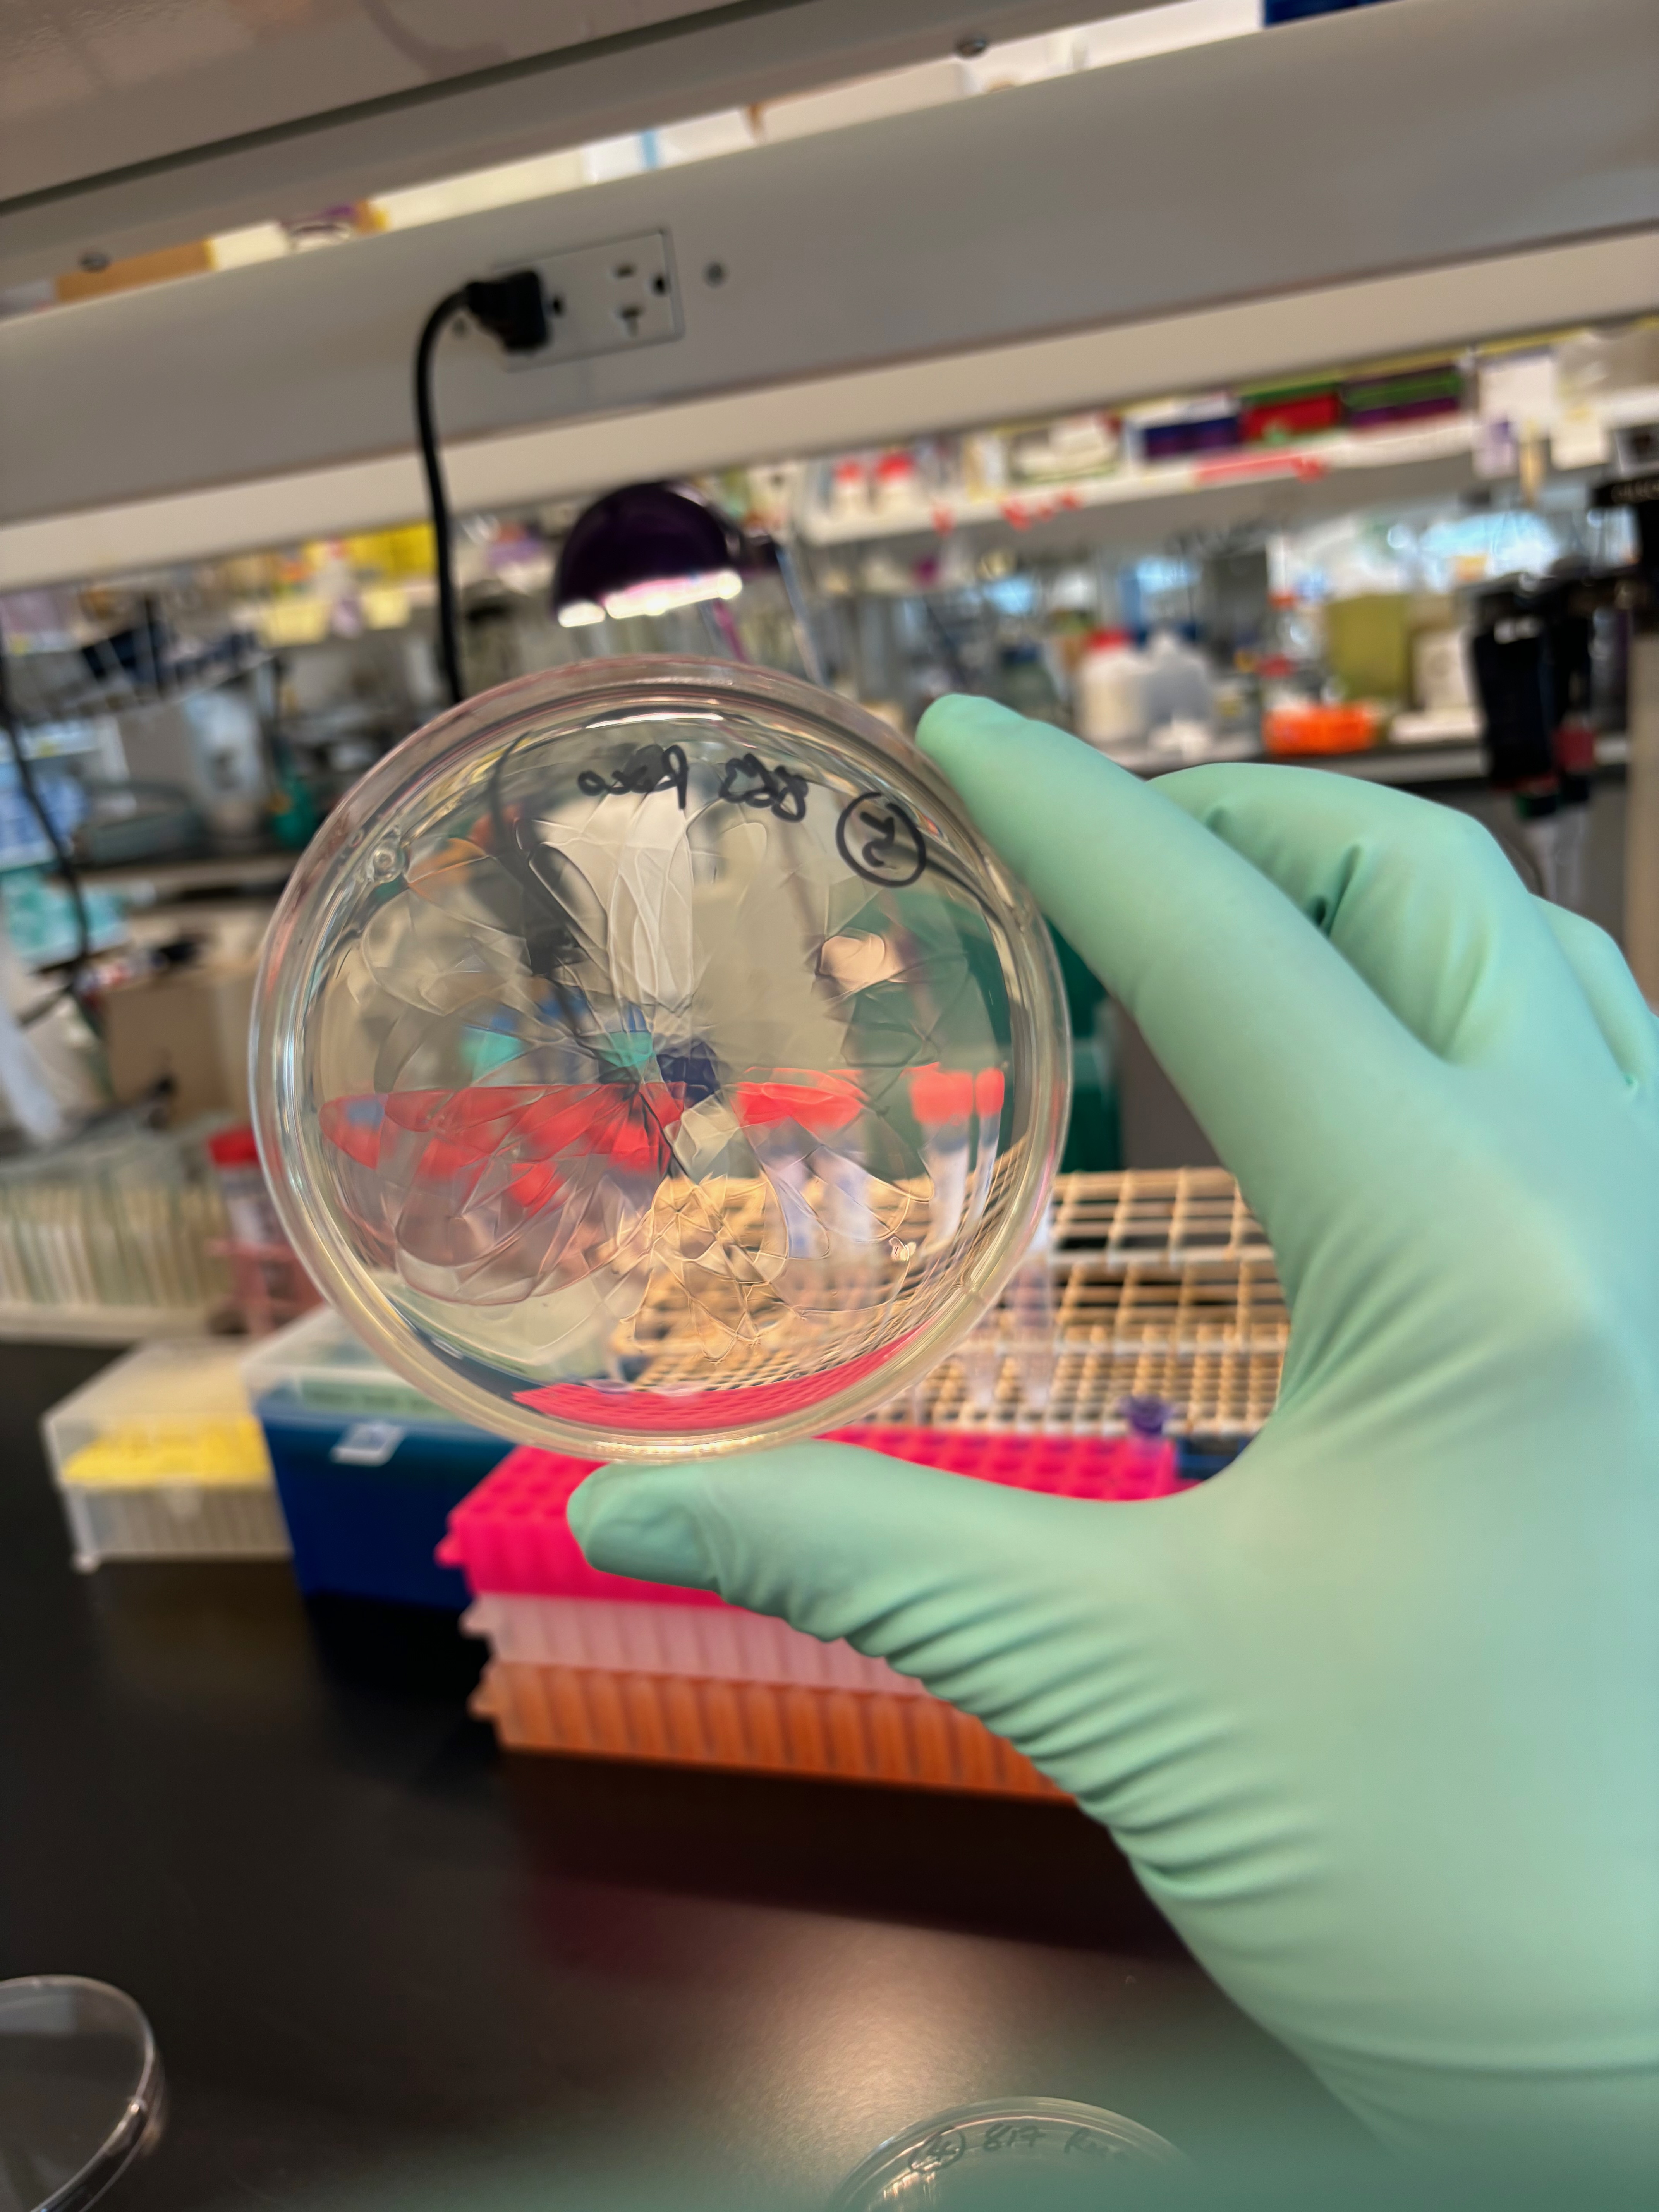

+86-186-2137-1179
ryder@ryderwhittakerhawkins.com
Working with a cohort of over 500 children with difficult or unsolved cases of pediatric IBD, I am exploring the role of specific immune and developmental genes in causing gut inflammation. Current targets include the Toll-like receptor pathway in autoinflammatory arthritis and IBD, the NF-kB pathway and ubiquitin regulation, RhoGEFs and GTPases, and novel developmental serine/threonine kinases in Noonan-like syndromes.
* Gaibee Z, Warner N, Bugda Gwilt K, Li W, Guan R, Whittaker Hawkins R, ... Thiagarajah J, Muise AM. The genetic architecture of congenital diarrhea and enteropathy (CODE). NEJM 2025.
* Ghasempour S*, Warner N*, Guan R*, Rodari M*, Ivanochko D, Whittaker Hawkins R, ... Freeman SA, Parlato M, van Ham TJ, Muise AM. Bi-allelic ITGAV mutants are associated with immune dysregulation, brain abnormalities, and very early onset inflammatory bowel disease. J Exp Med 2024. doi: 10.1084/jem.20240546.
* Li Q*, Shen X*, Hu Y*, Long K, Whittaker Hawkins R, Nambu R, Guan R, Warner N, Guo C, Li W, ... Li D, Klein C, Kotlarz D, Muise AM. BIRC3 (cIAP2) haploinsufficiency associated with pediatric and adult-onset Crohn's disease in humans and mice. In preparation NEJM
* Mech E, Maini P, Batura V, Natu A, Whittaker Hawkins R, Zhang S, Gaibee Z, Li W, Lam L, Guo C, Warner N, Muise AM. Characterization of novel gain-of-function mutations in the cytoplasmic tyrosine kinase ZAP70 in multi-organ immune dysregulation and inflammatory colitis. In preparation Nat Genet
* Kong W*, Whittaker Hawkins R*, Guo C, Wang L, Deng X, Zhou S, Duan X, Lyu X, Muise AM, Wang Z. Loss of function in the immune regulator IRAK3 associated with early onset IBD. In preparation JACI
* Whittaker Hawkins R, Li Q, Warner N, Guan R, Giralt L, Muise AM. TLR2 TIR domain mutations cause very early onset IBD and autoinflammation. In preparation NEJM
* Whittaker Hawkins R, Guo C, Guan R, Warner N, Giralt L, Li W, St Germain J, Raught B, Pan J, Li Q, Zhang S, Gaibee Z, Thoeni C, Nieuwenhuis E, Turner D, Lev-Tzion R, Muise AM. DAPK1 Roc domain mutations cause loss of GTPase activity and veoIBD with developmental defects. In preparation Gastroenterology/JBC.
--->
With Dr. Robert Rottapel and Dr. Tian Sun, we were called upon to solve a childhood case of autoinflammation responsive to anakinra (IL-1b inhibition). The patient bears a homozygous mutation in the small GTPase Cdc42. We found that the C188Y mutation blocks lipidation and trafficking of Cdc42 to the plasma membrane, causing rewiring of the interactome, failure to mobilize actin, and impinging on the inflammasome system to cause inflammation.
* 09/2022 – “Cdc42 regulation of actin revealed by autoinflammatory mutation”. Invited talk, Protein regulation seminar series, UofT
* 04/2022 - Whittaker Hawkins R. The life, death and afterlife of lab hustle. IMMPress Magazine 2022. https://lnkd.in/gr4zhxDU

Another focus of the Rottapel lab is understanding how cancers adapt and resist chemotherapies. Specifically, high-grade ovarian carcinoma cells are addicted to the GCN2 stress-response pathway. Originally a method for sensing amino acid deprivation and initiating survival mechanisms, SKOV3 cells use this pathway as a crutch to withstand the stresses of the ascites environment, the effects of cisplatin chemotherapy, and proteotoxic and genotoxic stress. I used RNA-seq to map the cisplatin response in cellulo and pinpoint effectors of GCN2 in this pathway.
Further, with Dr. Kyle Francis, I analyzed RNA-seq and ChIP-seq to understand how ovarian cancers use nonsense-mediated decay to both clear endogenous retrovirus DNA and deal with increases in toxic transcripts during chemotherapy. With OICR, Kyle is planning to develop specific inhibitors of this pathway.
With Dr. Mich He from Melbourne, we investigated how leukemia cells adapt by using the G protein GNAS to survive.
* He M, Tong K, Liu T, Whittaker Hawkins R, ... He HH, Kridel R. GNAS knockout potentiates HDAC3 inhibition through viral mimicry-related interferon responses in lymphoma. Leukemia 2024. doi: 10.1038/s41375-024-02325-4

At the Toronto Academy of Art on Dundas St. and later with TEACH Tutoring Co., I developed a holistic teaching philosophy grounded in classic texts and bridging disciplines to prepare students for 21st-century Canadian life. French, English, Mathematics and Science were blended with History, Philosophy, Music and Art to propel students to make connections and develop their unique perspective and opinions.

In Quebec City, I worked at the CHUL in Dr. Luc Vallieres lab. This was my first taste of immunology and mouse work. We showed that a subset of ICAM1+ neutrophils are essential to the initiation and progression of chronic EAE, a model of multiple sclerosis. Thus, the innate immune system is critical for autoimmunity, not just T and B cells.
* Whittaker Hawkins R, Patenaude A, Dumas A, Jain R, Tesfagiorgis Y, Kerfoot S, Matsui T, Gunzer M, Poubelle PE, Larochelle C, Pelletier M, Vallieres L. ICAM1+ neutrophils promote chronic inflammation via ASPRV1 in B cell–dependent autoimmune encephalomyelitis. JCI Insight 2017. doi: 10.1172/jci.insight.96882.
* Casserly C, Nantes J, Whittaker Hawkins R, Vallieres L. Neutrophil perversion in demyelinating autoimmune diseases: Mechanisms to medicine. Autoimmun. Rev. 2017. doi: 10.1016/j.autrev.2017.01.013.
During my undergraduate at Canada's top university, UofT, and Trinity College, I was funded by the NSERC to undertake basic research into protein science, autophagy, and C. elegans genetics. I defended my fourth-year thesis and served on the Chemistry Students' Union.
• Undergraduate thesis: Elucidated a developmental signaling pathway in C. elegans under Dr. Peter Roy. Showed for the first time that the MADD-4 developmental cue relies on sulfation of the extracellular matrix by HST-3.1. Honed techniques of Western blotting, PCR genotyping, and model organism culture. Defended my year-long thesis project before a committee of faculty.
• NSERC USRA, 2014: Identified the deubiquitinases A20 and ataxin-3 as potential protective genes in mitophagy with Dr. Angus McQuibban. Learned basic techniques in mammalian cell culture and Western blotting.
• NSERC USRA, 2013: Helped to rationally design photoswitchable proteins with Dr. Andrew Woolley. Applied my chemical knowledge to protein purification, electrophoretic shift assays, and bacterial culture.